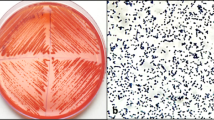

Abstract
Environmental contamination with aromatic compounds is a universal challenge. Aromatic-degrading microorganisms isolated from the same or similar polluted environments seem to be more suitable for bioremediation. Moreover, microorganisms adapted to contaminated environments are able to use toxic compounds as the sole sources of carbon and energy. An indigenous strain of Pseudomonas, isolated from the Mahshahr Petrochemical plant in the Khuzestan province, southwest of Iran, was studied genetically. It was characterized as a novel Gram-negative, aerobic, halotolerant, rod-shaped bacterium designated Pseudomonas YKJ, which was resistant to chloramphenicol and ampicillin. Genome of the strain was completely sequenced using Illumina technology to identify its genetic characteristics. MLST analysis revealed that the YKJ strain belongs to the genus Pseudomonas indicating the highest sequence similarity with Pseudomonas pseudoalcaligenes strain CECT 5344 (99% identity). Core- and pan-genome analysis indicated that P. pseudoalcaligenes contains 1,671 core and 3,935 unique genes for coding DNA sequences. The metabolic and degradation pathways for aromatic pollutants were investigated using the NCBI and KEGG databases. Genomic and experimental analyses showed that the YKJ strain is able to degrade certain aromatic compounds including bisphenol A, phenol, benzoate, styrene, xylene, benzene and chlorobenzene. Moreover, antibiotic resistance and chemotaxis properties of the YKJ strain were found to be controlled by two-component regulatory systems.
Similar content being viewed by others
Introduction
Environmental pollution is considered an important threat to the ecosystem1, influencing all organisms and human health extensively1,2. Traditionally, wastewaters and effluents are treated with chemical and physical methods. However, microbial decomposition of pollutants has also been widely investigated. Microbial degradation provides the possibility of complete mineralization of organic compounds3. Hence, bioremediation can be noted as a sort of medicine for the environment that can be applied to remedy polluted sites1. A large number of malicious organic compounds including halogenated aliphatics, pesticides and aromatic compounds such as benzene, xylene, toluene, phenolic compounds and their derivatives have been identified in the environment4. These contaminants are decomposed by a wide range of microorganisms including fungi, bacteria and yeasts3,5. Indigenous microorganisms from contaminated environments with the same type of pollutants are preferred for bioremediation of contaminants because they are adapted and can tolerate harsh environmental conditions and, therefore, may have more incentive to attack the pollutants1. Generally, a diverse set of catabolic enzymes involved in the conversion of aromatic compounds to Krebs cycle intermediates through the ortho- or meta-cleavage pathways, depend on bacterial genetic characteristics6,7.
Pseudomonas is a genus of Gram-negative, aerobic bacteria, containing several species that have been isolated from various environments, such as water and soil8,9. Some Pseudomonas species are capable of metabolizing chemical pollutants in the environment, and as a result, can be utilized for bioremediation8. In fact, Pseudomonas alcaligenes, Pseudomonas mendocina, Pseuodomonas resinovorans and Pseudomonas pseudoalcaligenes have been reported as suitable bioremediation agents10,11,12. In a recent research by Jahanshahi et al., the Pseudomonas YKJ strain was found to grow in presence of some aromatic pollutants as the only sources of carbon and energy13.
The genetic characterization of microorganisms isolated from the environment is momentous for conception of genetic mechanisms of adaptation processes, and regulatory and structural genes of catabolic pathways involved in environmental processes and application14,15,16,17. The advent of next generation sequencing (NGS) technologies, accompanied with the development of many new assembling methods and software programs, can provide access to the whole-genome sequence of a microorganism in a much shorter period of time and at lower costs than the traditional sanger sequencing method18,19. It is used for various purposes16 including evaluation of the presence or absence of a catabolic pathway in microorganisms20.
In this study, the whole-genome sequence analysis of a previously isolated indigenous pseudomonas YKJ strain (GenBank accession no. KR229982) was carried out and compared with seven most similar strains using core- and pan-genome, and phylogenetic analyses to determine target genes and pathways related to the advantageous interactions between bacteria and their surrounding environment including genes involved in aromatic compound degradation pathways and regulatory systems in response to the chemical compounds (Fig. 1).
Workflow of the sequencing and analysis of the YKJ genome. It comprises sample preparation, next-generation sequencing (NGS) and data analyses including genome assembly, mapping reads, gene annotation, phylogenetic studies and identification and extraction of the plasmid DNA sequence. As shown in the flow chart, reads were mapped against the reference genome through filtering and trimming processes and were de novo assembled to determine a draft genome assembly. Subsequent analyses were carried out on the resulting YKJ genome.
Results
DNA extraction
High quality genomic DNA of Pseudomonas YKJ strain, suitable for sequencing and molecular experiments, was extracted and used for NGS and amplification of the 16 s rRNA gene (Fig. S1–1).
Genome sequencing and assembly
The qualified DNA was sequenced using the paired-end sequencing approach through a HiSeq 2000 sequencing Platform. A library of DNA fragments, 350 bp in size, was constructed and used for sequencing in both directions which resulted in 612,945,871 reads with an average length of 101 bp and G + C content of 63% (Table S2). The reads were filtered by removing low quality bases (≤Q20), repetitious contamination and trimming of 5′ ends to attain suitable conditions for analysis (Fig. S2). The cleaned reads were then analyzed using two approaches to assemble the genome. The Velvet assembler produced 592 contigs with an N50 size of 27295 bp and total size of 4.6 Mbp, using k-mers of 65. While, the genome sequence acquired through the SPAdes assembler revealed better results in assembly, consisting of 140 contigs (>500 bp) with lengths ranging from 687 to 307845 bp and an N50 size of 96476 bp, which ultimately resulted in a total length of 4,905,549 bp using k-mers of 65. Therefore, 140 scaffolds were considered as the genome of the strain (Table S3). Consequently, scaffolds created via the SPAdes assembler were annotated to detect target genes and pathways, which were then registered in the NCBI databank under the accession number PTLV00000000. In addition, BUSCO assessment showed that 99.8% of the genome was fully obtained.
Phylogenetic analysis
Comparison of the 16S rRNA gene isolated from the YKJ draft scaffold against the NCBI 16S rRNA genes database showed that the YKJ strain belonged to the genus Pseudomonas, with Chengduensis being identified as the closest species (99%) (Table S4), which was consistent with the results reported by Jahanshahi et al.13. But, phylogenetic analysis of the individual rpoD, rpoB, and gyrB genes sequences as well as the 16S rRNA gene sequence in the PseudoMLSA database revealed that the strain YKJ belongs to the genus Pseudomonas and most closely resembles the pseudoalcaligenes species, strain CECT5344 (Table S5). Consequently, the mapping and MLST results were confirmed by CVTree and PhyloSift analyses (Figs 2 and 3), which state that the target strain belongs to the genus and species of pseudomonas pseudoalcaligenes.
Pseudomonas pseudoalcaligenes YKJ genome features and whole-genome comparison
The percentage of matching reads to the 7 relevant genomes was investigated to find the best reference genome (Fig. S3). Ultimately, the P. pseudoalcaligenes strain CECT5344 (GenBank: GCA_000297075.2) was selected as the closest strain with alignments of over 63% of the reads (Table S9).
The draft genome assembly of P. pseudoalcaligenes YKJ includes a single circular chromosome of 4.9 Mbp with an average GC content of 63%. In total, 4583 genes were predicted in this genome, encoding 4565 putative coding sequences (CDS). Moreover, 48 tRNA genes and 3 rRNA genes were predicted in the chromosome sequence. The complete characteristics of P. pseudoalcaligenes YKJ and seven closely-related genomes are presented in Supplemental Table S7, and Figs 4 and 5. Accordingly, based on genomic sequence and other features including the genome size, total number of genes and total predicted CDS, P. pseudoalcaligenes YKJ is considered as the strain most similar to P. pseudoalcaligenes CECT5344.
Genome comparisons of Pseudomonas pseudoalcaligenes YKJ and other P. pseudoalcaligenes strains against strain CECT5344 as the reference genome created by BRIG v0.95, the circular graph demonstrates the whole genome comparison of strain CECT5344 with the other seven closely-related genomes of P. pseudoalcaligenes. The inner black circle reveals the complete reference genome (strain CECT5344) and the intensity of each color indicates the similarity of that strain with the reference genome.
Using Mauve analysis, we found 9 collinear blocks between concatenated chromosomes of two strains (Fig. 6), showing several inversion and rearrangement structures. In addition, the chromosomal alignments showed existence of large segments with high similarity. Moreover, a region of approximately 2 Mb between contigs 4 to 8 in the YKJ chromosomal scaffolds displayed inversion, revealing different reciprocal relationships to the reference sequence. It was also shown that the YKJ chromosomal scaffolds have an insertion region between contigs 5 to 7.
Pan- and core-genome analysis of P. pseudoalcaligenes YKJ
A pan-genome analysis for YKJ and the 7 sequenced P. pseudoalcaligenes strains was performed using the Roary tool based on comparison of the translated CDS set. The genome of 8 P. pseudoalcaligenes strains comprised a total of 13,431 genes consisting of 1,671 genes in the core-genome and 11,760 genes in the accessory genome, including 7,443 shell genes (moderately common in the pan-genome) and 4,317 cloud genes (present in very few analyzed genomes). With regard to the accessory genome, 3,935 genes are present in the unique genomes, indicating the existence of specific genes among the P. pseudoalcaligenes strains. The lowest numbers of unique genes belonged to the Pac, CECT5344 and KF707 strains, with 16, 22 and 47 genes, respectively. Strains S1, NBRC14167, AD6 and KF707_a1 contained the highest numbers of specific genes as well (Fig. 7). The target genome (YKJ strain) contained 238 unique genes, 97 of which have been predicted to encode hypothetical proteins (Table S8).
The ability of the YKJ strain to use aromatic compounds (pollutants) as carbon and energy sources was also analyzed. This strain contains all the genes that contribute to the ortho-cleavage pathway. Furthermore, it contains the full complement of genes involved in the meta-cleavage pathway. The tfdS and glpF genes were also identified in the YKJ strain, which act as transcriptional activator for the bauABCD operon21 and glycerol-3-phosphate regulon repressor22, respectively. Moreover, 34 known genes belonging to transcription regulators, hydrolases, the toxin-antitoxin system and transferases were also identified. (Table S8).
Relatedness of Pseudomonas pseudoalcaligenes YKJ based on core- and pan-genome analysis
The phylogenetic relationship of P. pseudoalcaligenes YKJ and the other seven P. pseudoalcaligenes strains were revealed based on the core- and pan-genome analysis. As shown in Fig. 8B, P. pseudoalcaligenes YKJ is clustered in a separate clade based on the pan-genome analysis, which is genetically close to the KF707_a1 and KF707 strains. A phylogenetic tree was also created using the amino acid sequences of 1671 genes in the core-genome, which showed the clustering of the YKJ strain in a separate clade, with a close phylogenetic relationship between the YKJ and Pac, NBRC14167 and CECT5344 strains. Furthermore, this analysis also revealed a distant phylogenetic relationship between NBRC14167 and KF707_a1 and KF707 strains that were placed in the same clade (Fig. 8A).
Pathway analysis
Annotation of the P. pseudoalcaligenes YKJ genome led to prediction of approximate biochemical, catabolic and biosynthetic pathways, as shown in Supplemental Fig. S4. Classification of the metabolism groups also revealed genes involved in each group (Fig. S5). Genome annotation identified key genes associated with the metabolism of aromatic compounds, II and IV secretion systems, antibiotic resistance, and carbon metabolism, etc. (Tables S10–S14).
Aromatic compound degradation pathways
Analysis of the YKJ strain genomic data identified approximately 117 candidate genes probably involved in the degradation of benzene, chlorobenzene, xylene, styrene, benzoic acid, phenol and bisphenol A. The data also revealed S-hydroxymethyl dehydrogenase and alcohol dehydrogenase genes, as well as ammonia monooxygenase and flavin-dependent monooxygenase genes, which contribute to the conversion of aromatic compounds to catechol (Table S10). However, the YKJ genome also possesses both catechol 1, 2-dioxygenase and catechol 2, 3-dioxygenase genes which are involved in the degradation of catechol in the ortho- and meta-cleavage pathways, respectively (Table S9). As reported in Supplemental Table S9, the YKJ strain genome contains all the genes implicated in the ortho- and meta-cleavage pathways. In addition, we could not find a complete group of genes related to toluene degradation.
Secretion systems
Two outer-membrane protein secretion systems consisting of types II and IV, as well as the Tat (twin arginine translocation) and Sec-SRP (general secretory pathway) systems were identified in the YKJ genome. All genes encoding protein subunits involved in the T4SS, T2SS and Sec-SRP systems were detected in the YKJ genome (Table S11, Fig. 9), whereas only the tolC gene related to the type I secretion systems (TISS) was identified in this strain.
Schematic overview of metabolic pathways of P. pseudoalcaligenes YKJ. The described pathways were found on the basis of genomic data, indicating the strain contains genes related to the ability of degrading aromatic compounds. A complete carbohydrate metabolic route including glycolysis, gluconeogenesis, Krebs cycle, the pentose phosphate pathway (PPP) and pyruvate metabolism are also present in the YKJ genome. The latter comprises the genes contributing to the secretion systems involving T4SS, T2SS, Tat and Sec-SRP systems. Several genes related to two-component regulatory systems are also available in the YKJ strain.
Quorum sensing
We found 94 genes related to two-component regulatory systems in the YKJ genome, such as the PhoP-PhoQ, PhoR-PhoB, NtrB-NtrC and CheA-CheYBV systems (Table S12, Fig. 9). The YKJ genome also contains 41 genes involved in the quorum sensing process, which may act directly through these genes or indirectly through cellular metabolism (Table S13). Of those genes, qseC and qseB genes are the membrane sensor kinase and response regulator of the two-component QseB-QseC signaling system, respectively. The QseC enzyme responds to bacterial signals by phosphorylating the QseB response regulator, leading to its activation and positive regulation of flagella and motility genes23,24. In addition, the qseC and qseB genes are components of the quorum-sensing system, which could mean that the quorum-sensing and two-component systems interact with each other25.
Antibiotic resistance in the YKJ strain
By interpreting the genomic data from the YKJ strain, we found approximately 31 candidate genes implicated in antibiotic resistance pathways (Table S14). These included genes that encode beta-lactamases and chloramphenicol acetyltransferases, which allow bacteria to grow in the presence of ampicillin and chloramphenicol antibiotics, respectively26.
YKJ plasmid DNA detection and assembly
Plasmid sequence was separately acquired in 39 scaffolds (≥500 bp), which resulted in a total length of 276,024 bp with an N50 size of 12,722 bp. Using the PlasmidFinder server, the incompatibility (Inc) group of the plasmid from the YKJ strain (pYKJ) was identified as the Incp1 (beta) group. pR751 was also recognized as the closest plasmid to pYKJ (Table S15).
Comparison of pYKJ nucleotide sequence with eight other plasmids, namely pRms149, pTOM9, pKLC102, pRA2, pDK1, pWW53, pPME5 and pR751, revealed their similarities and differences (Figs S6 and S7).
YKJ plasmid DNA annotation
Analysis of the pYKJ scaffold in Addgene server indicated the presence of Pmel and Swal restriction enzymes sites, as well as ORFs (Fig. S8). Moreover, annotation of the pYKJ scaffold recognized all genes encoding type IV secretion system proteins associated with conjugative plasmid transfer (Table S16). As presented in the Supplemental Table S17, antibiotic resistance genes are not present on pYKJ and several genes are of genomic origin. In total, 262 protein CDS and eight tRNA-coding genes were identified in the pYKJ plasmid.
Experimental analysis of aromatic compound degradation pathways
Performance of the degradation pathways found in the YKJ strain through sequence analysis was investigated by growth in mineral salts medium supplemented with different aromatic compounds as sole sources of carbon and energy.
The growth of bacterial cultures (OD600) revealed that the YKJ strain is able to grow in the presence of bisphenol A, phenol, styrene, xylene, benzene, chlorobenzene and benzoic acid. Furthermore, using various concentrations of each pollutant indicated that the YKJ strain is capable of growing at specific concentrations (Fig. S9). Accordingly, we identified the relevant concentrations (Table S18) of aromatic compounds as the sole sources of carbon and energy, which enabled maximum growth of the YKJ strain. Hence, this strain is more capable of decomposing and consuming bisphenol A, phenol and styrene as the only sources of carbon and energy than xylene, benzene, chlorobenzene and benzoic acid (Fig. S10).
Antibiotic resistance in the YKJ strain
Antibiotic resistance was investigated via cultivation of the strain on LB agar medium containing an antibiotic. According to the results, the YKJ strain is resistant to ampicillin and chloramphenicol while the growth intensity of this strain was higher on the LB agar medium supplemented with chloramphenicol (Table S19). The results confirmed the function of the predicted genes encoding β-lactamase and chloramphenicol acetyltransferase.
The antibiotic resistance was also investigated after transfer of pYKJ into E. coli DH5α, which showed no growth of transformants on ampicillin- and chloramphenicol-containing media. The presence of pYKJ in the five antibiotic sensitive transformants was verified by plasmid extraction and agarose gel electrophoresis (Fig. S11).
Discussion
In this study, we carried out in silico, genetic and biochemical characterization of an indigenous Pseudomonas YKJ strain through whole-genome sequencing. The genomic data was confirmed and supported by experimental tests. The comparative genomic analysis of P. pseudoalcaligenes YKJ and seven previously sequenced P. pseudoalcaligenes strains revealed high similarity amongst them, particularly the Pac, CECT5344 and NBRC14167 strains. According to the pan-genome analysis, the YKJ strain was genetically clustered in a separate clade close to the KF707_a1 and KF707 strains, which are clustered in the same clade (Fig. 8B). Moreover, a phylogenetic tree based on the amino acid sequences of 1671 genes of the core-genome demonstrated low diversity between the studied strains, revealing their evolution from a common ancestry (Fig. 8A).
There are two main strategies to decompose aromatics, which are dependent on the absence or presence of oxygen27. Under aerobic conditions, biodegradation is carried out via the ortho- or meta-cleavage pathways28. The main genes involved in the meta-cleavage pathway include the dmpB, dmpC and dmpD genes encoding catechol 2,3-dioxygenase, 2-hydroxymuconic semi-aldehyde dehydrogenase and 2-hydroxymuconic semi-aldehyde hydrolase, respectively29. In addition, the catRBCA gene cluster is involved in the ortho-cleavage pathway that converts catechols to 3-oxoadipate intermediates30. Here, our studies revealed that the YKJ strain contains the catRBCA gene cluster and all the other genes associated with the meta-cleavage pathway (Table S9). Pan-genome analysis of eight strains revealed the presence of the complete catRBCA gene cluster in only five strains, namely, strains YKJ, AD6, KF707_a1, KF707 and S1 (Table S8). Furthermore, the strain YKJ contains all the genes that play a part in the meta-cleavage pathway, whereas the dmpB, dmpC and dmpD genes are only present in the S1 strain genome.
The YKJ strain contains enzyme-coding genes involved in pathways that degrade certain aromatic compounds, namely phenol, bisphenol A, benzene, chlorobenzene, styrene, xylene and benzoic acid. Phenol degradation is reported in many Pseudomonas strains such as Pseudomonas sp. CF600, which grows efficiently on phenol using the meta-cleavage pathway encoded by the pVI150 plasmid carrying the dmpKBCIHEGF or dmpKBDEGF genes organized into operons7. The YKJ strain contains the complete dmpKBDCIHEGF genes (Table S10) in its genome and can grow on phenol as a preferred sole carbon and energy source (Figs S9b and S10).
Although, several pathways have been presented for aerobic degradation of bisphenol A, there have been few studies investigating genes and enzymes related to the BPA degradation pathways. The first BPA-degrading pathway was characterized in the Sphingomonas sp. strain MV131. A metabolic pathway for bisphenol A metabolism by Gram-negative bacteria32 has also been reported. In these studies, a cytochrome P450 monoxygenase in Sphingomonas, an ammonia monooxygenase (AMO) in Nitrosomonas europaea and an extracellular laccase in Pseudomonas have been also implicated in BPA degradation31,33. Thus, enzymes involved in BPA degradation have not yet been fully characterized. Based on the genomic analysis, the YKJ strain has been found to contain monoaxygenase-coding genes such as AMO. In addition, experimental results revealed that the YKJ strain is capable of growing on the medium containing BPA as the sole carbon and energy source (Fig. S9a). Our previous study13 showed that 4-hydroxyacetophenone, 4-hydroxybenzaldehyde and 4-hydroxybenzoic acid were all produced during BPA degradation by this strain. These BPA metabolites have been recorded in the BPA degradation pathway in the KEGG database (PATHWAY: map00363). Therefore, the genome of the YKJ strain contains genes encoding BPA degradation pathway enzymes, and the strain prefers to use bisphenol A (0.3 g/l) in addition to phenol (1 mM) and styrene (0.1% v/v) (Fig. S10). Since the amounts and activities of the enzymes contributing to the BPA degrading pathway are remarkably diverse in various bacterial strains31, it is essential to characterize the intermediates formed during the enzymatic degradation of BPA. Therefore, the new genes and enzymes involved in BPA decomposition need to be further investigated.
In a study on the degradation of aromatic compounds by the strain, Pseudomonas putida KT2440, benzoate is metabolized through conversion into catechol and then to Krebs cycle intermediates34 (ortho-cleavage) and can thus be used by the bacterium as a sole source of carbon and energy35. The analysis of YKJ strain genome indicates the presence of all dmpKBDCIHEGF genes involved in the ortho-cleavage pathways (Table S10), therefore, it should be capable of degrading benzoate. This was confirmed by the ability of the strain to grow in medium consisting of benzoate as the sole carbon and energy source (Fig. S9e). Degradation of chlorine- or methyl-substituted aromatic compounds derivatives, such as chlorobenzene36 is performed via two-enzymatic systems that include dioxygenases (upper pathway, attack the aromatic ring) and monooxygenase (lower pathway, attack the methyl or ethyl substituents of the aromatic ring)37. The xylUWCMABN operon (upper pathway) oxidizes methylbenzenes to methyl benzoates and the meta-operon (lower pathway, xylXYZLTEGFJQKII-I genes) converts methylbenzoates to pyruvate, acetaldehyde and acetate through the (methyl) pyrocatechols. Our study revealed that the xyl XYZLEGFJQKI genes are present in the YKJ genome (Table S10). Thus, it is predicted that this strain converts o- and m-xylene to acetaldehyde, and p-xylene to propanol through the lower pathway (meta-operon). Notably, the xylM and xylC genes which oxidize o-, m- and p-xylene to p-methylbenzaldehyde via the upper pathway38 are absent in the YKJ genome. Hence, this strain cannot decompose xylene by the upper pathway while growing on the medium containing xylene as the only carbon source (Fig. S9d), thereby confirming the possible ability of the strain to degrade xylene through the lower pathway or a new pathway that should be further investigated.
Benzene-degrading bacteria contain mono- or dioxygenase enzymes, which convert benzene to phenol or cis-benzodiazolidine and then to catechol, the ring structure of which is ultimately cleaved in the ortho or meta position39. The chlorobenzene degrading pathway in Pseudomonas P5140 is encoded by a plasmid-located transposon, Tn5280. Homology comparisons revealed that these genes are most closely related to the todC1C2BAD genes (toluene degradation) and bnzABCD genes (benzene degradation), and distantly to genes involved in biphenyl and benzoate degradation. Similar to enzymes in the toluene degradation route, chlorobenzene dioxygenase and cis-chlorobenzene dihydrodiol dehydrogenase were able to oxidize 1, 2-dichlorobenzene, biphenyl and toluene, but not benzoic acid, which strongly suggest that these two enzymes originated from a pathway degrading toluene or benzene, likely via horizontal gene transfer40. The YKJ genome encompasses the genes encoding catechol 1, 2-dioxygenase, chloromuconate cycloisomerase and dienelactone hydrolase enzymes, which convert 3-chlorocatechol to maleylacetate. However the genome does not contain the tcbA and tcbB genes, which oxidize chlorobenzene to 3-chlorocatechol41, and the genes encoding benzene 1,2-dioxygenase and cis-1,2-dihydrobenzene-1,2-diol dehydrogenase, which convert benzene to catechol42 (Table S10). Additionally, we found complete gene sets contributing to phenol degradation, such as the dmpK gene, encoding phenol hydroxylase, which converts benzene to phenol (PATHWAY: map00362). Therefore, it seems that this strain is capable of converting benzene to phenol in its degradation route. Furthermore, styrene dioxygenase and cis-1,2-dihydrobenzene-1,2-diol dehydrogenase enzymes responsible for the oxidation of styrene to 3-Vinylcatechol43, were absent, while the xylE, xylF, catA, gctA, gctB, feaB and pct genes were present in the YKJ genome (Table S10). Experimental data also revealed that this strain is capable of growth on chlorobenzene, benzene and styrene as the only sources of carbon and energy (Fig. S9c,f,g). Due to considerable variety and specific functional properties, various monooxygenase enzymes are able to degrade aromatic compounds by aromatic ring cleavage. For instance, a phenol hydroxylase belonging to the flavin-dependent monooxygenase family has been identified in Bacillus thermoglucosidasius A7, which catalyzes ortho-hydroxylation of phenol to catechol44. The vinyl side chain oxidation is catalyzed via a FAD-dependent styrene monooxygenase, leading to production of styrene epoxide45. Other microorganisms, such as Pseudomonas Pickettii PKO146, also use flavoprotein monooxygenases to hydrolyze phenol. Costa et al. have stated47 that mesophilic microorganisms are aerobically capable of catabolizing the xenobiotic aromatic compounds by adding a hydroxyl group to the ring. Accordingly, flavoprotein monooxygenases (FPMOs) are often employed to perform this primary catabolic phase. The resulting catechol can then be cleaved by metal ion-dependent dioxygenase enzymes, resulting in the further cleavage of products to generate energy early in the metabolic pathways48. So, these studies confirm that flavin-containing enzymes are involved in the microbial decomposition of aromatic compounds. The study of the YKJ genome revealed genes encoding flavin-dependent monooxygenase enzymes including flavin monooxygenase and ammonia monooxygenase, as well as aromatic ring-cleavage dioxygenase enzymes (Table S10). Therefore, it can be concluded that the YKJ strain probably catabolizes the primary steps of benzene, chlorobenzene, xylene and styrene degradation through flavin-dependent monooxygenases, resulting in the formation of the corresponding catechols. The catechols are then degraded through the ortho- or meta-cleavage pathway, and eventually converted to the Krebs cycle intermediates. Nevertheless, the YKJ strain tends to consume phenol, bisphenol A and styrene more than benzene, chlorobenzene, xylene and benzoic acid. Existence of the above discussed genes encoding aromatic compound-degrading enzymes in the genome of our strain (instead of the plasmid or transposon) makes it suitable for application in bioremediation of aromatic compounds.
During the primary characterization of the YKJ strain, the 16S rRNA gene study revealed that it belongs to the Pseudomonas chengduensis13 species. The mentioned 16S rRNA gene was aligned against the final scaffolds, which did not completely overlap with sequences existing in the scaffolds. As mentioned in some studies, bacterial classification based on the 16S rRNA gene has not yet reached its complete potential, because many microbial taxonomic groups have not been detected yet49. Therefore, the use of other methods was required to accurately determine the genus and species of the YKJ strain. MLST, which is a procedure for typing of multiple loci that distinguishes microbial isolates through the comparison of the housekeeping gene sequences, such as rpoD, rpoB and gyrB, at the genus and species level50, has been used for phylogenetic relationship studies51. Thus, analysis of housekeeping genes is the preferred method in demonstrating the phylogenetic relationships among microbial genera and species52. The MLST studies based on rpoD, rpoB and gyrB gene sequences indicated that the YKJ strain belongs to the genus Pseudomonas and species pseudoalcaligenes. Some new phylogenetic studies have been conducted on the basis of all proteins or genes sequences53. Therefore, the phylogenetic relevance of the YKJ strain and 22 other strains were also investigated by aligning protein sequences of all strains. Consequently, the YKJ strain belongs to the genus Pseudomonas and species pseudoalcaligenes (Fig. 3). Phylogenetic studies at the reads level also confirmed these results (Figs 2, S3). In conclusion, the YKJ strain is considered as a pseudoalcaligenes species belonging to the genus Pseudomonas.
Resistance to ampicillin and chloramphenicol in Gram-positive and Gram-negative bacteria is dependent on the presence of β-lactamases and chloramphenicol acetyltransferases, which hydrolyze ampicillin and chloramphenicol, respectively26. The YKJ strain contains nearly 31 genes, mainly catB and ampC genes, involved in antibiotic resistance (Table S14). Hence, we predicted that the YKJ strain is resistant to these antibiotics. Hence, the antibiotic resistance of the YKJ strain was investigated by cultivation of the bacterium on medium containing ampicillin, tetracycline, kanamycin, rifampicin and chloramphenicol. As reported in Supplemental Table S19, the YKJ strain is resistant to ampicillin and chloramphenicol. Genome-encoded antibiotic resistance lessens the possibility of the horizontal transfer of the antibiotic resistance genes, which again makes this strain more suitable for environmental application.
Type IV secretion systems are diverse multi-functional systems with similar function in Gram-positive and Gram-negative bacteria54, which are usually composed of 12 subunits that are connected to an ATPase system in the membrane. Our study revealed that the YKJ strain contains all the genes (Table S11) encoding the protein subunits related to the VirB/D type IV secretion system55. The YKJ strain also comprises 12 gsp genes encoding the type II secretion system components (Table S11). Moreover, the gsp gene identification codes were found based on the KEGG Orthology (KO) database.
The general Sec-SR and Tat secretion pathways are frequently used by bacterial cells to transfer proteins across the cytoplasmic membrane. As presented in the Supplemental Table S11, the YKJ strain contains a family of sec genes that include the secY and secE genes encoding integral membrane proteins, and a sec A gene encoding an ATPase protein that acts as a molecular motor56. It also contains the SecB-coding gene, which functions as a chaperone to guide secretory proteins to the Sec-translocase57. We also found tatA, tatB and tatC genes in the YKJ genome (Table S11).
Two-component regulatory systems are widely present in bacteria that assist them in adapting to environmental conditions58. These regulatory systems monitor the internal and external signals and regulate various cellular processes, such as antibiotic resistance, metabolite utilization, reaction to environmental stress and sporulation59. In this study, we found 93 genes in the YKJ genome which are probably involved in the two-component regulatory pathways (Table S12). Among them, we can point to two important systems including CheA-CheYBV and PhoP-PhoQ. As reported by Gooderham, the pathogenicity and antibiotic resistance of Pseudomonas aeruginosa is controlled by the PhoP-PhoQ system which regulates resistance to aminoglycosides, polymyxin B and antimicrobial peptides60. On the other hand, the role of the CheA-CheYBV system in response to a variety of chemical and physical stimuli from the environment has been indicated in Escherichia coli and Salmonella typhimurium61. Since the YKJ strain is resistant to some antibiotics and is capable of growing on certain aromatic compounds as sole carbon and energy sources, by acquiring these two systems, it might be capable of responding to chemical stimuli controlled by the CheA-CheYBV system and antibiotic resistance monitored by the PhoR-PhoQ system.
Although, the antibiotic resistance genes such as those coding for chloramphenicol acetyltransferase and β-lactamase are generally located on episomal DNAs26, these genes are detected on the chromosomal DNA in the YKJ strain (Table S17). Hence, the YKJ plasmid comprises no antibiotic resistance genes which has been confirmed through the transfer of the pYKJ plasmid into E.coli DH5α. There are several studies indicating the presence of genes involved in aromatic compound degradation pathways on plasmids7,40. Our results showed that as well as antibiotic resistance genes, the YKJ chromosomal DNA contains all the relevant genes involved in the aromatic compound degradation pathways. Hence chromosol location of such genes can be considered a positive feature and an advantage for the environmental application of this strain, because the possibility of transferring and losing these genes ought to be relatively low. Moreover, these two features, aromatic compound degradation and antibiotic resistance, were preserved in the studied experimental population of the strain over many consecutive generations. In addition, many of the reported genes in Supplemental Table S17 are related to genomic DNA rather than plasmid.
Conclusion
In this study, we sequenced and analyzed the whole genome of an indigenous Pseudomonas sp., namely YKJ that was able to degrade phenolic compounds. Phylogenetic studies based on the housekeeping and all gene sequences indicated that the YKJ strain belongs to Pseudomonas pseudoalcaligenes. The whole-genome comparison of P. pseudoalcaligenes YKJ and seven closely related pseudoalcaligenes strains indicated 3935 and 1671 CDS as accessory and core-conserved genes, respectively. Investigation of its metabolic features revealed the YKJ’s ability to degrade several aromatic compounds either through the meta- or ortho-cleavage pathways. This strain contains antibiotic resistance genes including ampC and catB that code for the β-lactamase and Chloramphenicol acetyltransferase enzymes, respectively. Furthermore, the YKJ genome comprises a set of genes encoding the T4SS, T2SS, Tat and Sec-SRP systems. Hence, the YKJ strain is able to degrade aromatic compounds, which will make it highly suitable for application in bioremediation of polluted environments.
Materials and Methods
Bacterium, media and culture conditions
The bacterium under study was previously isolated from an industrial zone in Mahshahr, south of Iran by Jahanshahi et al. in 2014. It was identified as a member of the genus Pseudomonas, and designated as the Pseudomonas YKJ strain, capable of utilizing BPA as a sole carbon and energy source13. In order to investigate the degradation of aromatic compounds, Pseudomonas sp. YKJ was inoculated into liquid mineral salts medium (1.3 g K2HPO4.3H2O, 1 g (NH4)2SO4, 0.2 g MgSO4.7H2O, 0.016 g FeCl3.6H2O, 0.050 g CaCl2, 40 g NaCl per litre, and appropriate amounts of the aromatic compounds) and incubated at 30 °C and with shaking at 200 rpm. For preparation of fresh culture, bacteria were streaked onto LB agar medium (10 g tryptone, 5 g yeast extract and 10 g NaCl, 15 g agar per liter) and incubated at 30 °C. Pure cultures obtained on LB agar medium were used for preparation and storage of stock cultures in 30% glycerol at −70 °C.
DNA extraction
A single colony of the Pseudomonas YKJ strain grown on LB agar medium was inoculated into LB broth (10 g tryptone, 10 g NaCl and 5 g yeast extract per litre) and incubated at 30 °C with shaking at 180 rpm for 20 h. Bacterial cells were harvested by centrifugation. Genomic and plasmid DNAs were extracted via the DNA FAST extraction kit (Qiagen, CA, USA) and Fermentas plasmid extraction kit (Fermentas/ThermoFisher Scientific, USA), respectively, and in accordance with manufacturer’s instructions. DNA extraction was confirmed by agarose gel electrophoresis. DNA quality was also determined using a NanoDropTM spectrophotometer (Thermo Scientific NanoDrop 2000c, USA). In order to further evaluate the quality of the genomic DNA, PCR was performed for the 16S rRNA gene using B1 (AGAGTTTGATCCTGGCTTAG) and B2 (TAAGGAGGTGATCCAGC) universal primers62,63.
Workflow for sequencing of the YKJ genome
Bacterial culture, genomic DNA preparation, next-generation sequencing (NGS), de novo genome assembly and merging of contigs and subsequent bioinformatics analyses workflow are explained in detail below. Figure 1 presents a flow chart for the complete workflow.
Genome sequencing, assembly and annotation
The genome sequencing of Pseudomonas YKJ was carried out by Macrogen public biotechnology Co., Ltd.(Seoul, South Korea) using the HiSeq 2000 sequencing platform (Illumina Inc., San Diego, CA). The DNA sample was used to produce a pair-end sequencing library with an average size of 350 bp. Low quality sequence data were filtered and trimmed using the FastQC V0.10.1 (https://www.bioinformatics.babraham.ac.uk/projects/fastqc/) and Trimmomatic V0.36 tools (http://www.usadellab.org/cms/index.php?page=trimmomatic). The cleaned reads were then assembled in k-mer lengths of 31, 41, 47, 53, 59, 65, 67, 71, 77, 87 and 91 using the Velvet-1.2.1064 and SPAdes 3.9.0 programs65. Prodigal-2.6.3 software (http://compbio.ornl.gov/prodigal/) was employed to predict genes. Moreover, the quality of this de novo assembly was assessed by BUSCO v3 tools (https://gitlab.com/ezlab/busco). The genome annotation of the ordered assembled genome as well as gene detection were carried out by using the RAST (http://rast.nmpdr.org/) and BlastKOALA v2.166 servers. CDS, tRNA and rRNA features of the genome were also filtered and reported using the FeatureExtract 1.2L Server (http://www.cbs.dtu.dk/services/FeatureExtract/).
Pathway analysis
The predicted gene sequences were examined to detect the existence of certain metabolic pathways. Hence, the corresponding pathways were completely identified through manual examination of the determined genes functions based on comparisons with the KEGG (Kyoto Encyclopedia of Genes and Genomes) PATHWAY Database67. The identified pathways were graphically illustrated using PathVisio 3.2.0, (http://www.pathvisio.org/).
Phylogenetic analysis
MLST studies50 based on analysis of housekeeping genes were performed to identify the genus and species of the YKJ strain. Phylosift v1.0.1 software (http://phylosift.wordpress.com) was also applied to indicate phylogenetic models. Consequently, a phylogenetic tree was reconstructed based on the aligned sequences of whole genomes using the bootstrap method available in CVTree_V3.0 (http://tlife.fudan.edu.cn/cvtree/cvtree3/).
Whole genome comparisons
Based on phylogenetic analysis results, seven P. pseudoalcaligenes genomes were selected to identify the closest reference genome using the Bowtie2 v2.1.0 software68. Moreover, several genomic features including the number of genes, number of tRNAs and rRNAs, genome size and GC contents of the participating seven strains were compared using the NCBI databases. In order to find the closest reference genome, all reads were mapped to each of the seven P.pseudoalcaligenes strains, namely CECT5344, NBRC14167, AD6, S1, KF707, KF707_a1 and Pac. The seven genomes of the P. pseudoalcaligenes strains were aligned and compared with the YKJ draft scaffold assembly using the BRIG 0.95 application (http://brig.sourceforge.net/). We also oriented and compared the genomic sequence of the YKJ strain to that of the P. pseudoalcaligenes CECT5344 strain using the progressive Mauve program available in the Mauve V2.0 software (http://darlinglab.org/mauve/download.html).
Pan- and core-genome analysis
Roary v3.0, a prokaryote pan-genome pipeline, (http://sanger-pathogens.github.io/Roary) was used to accomplish Pan- and core- genome analysis of P. pseudoalcaligenes strains comprising the YKJ and its seven close strains. Additionally, a phylogenetic tree was created using Roary, based on the presence and absence of core and unique genes.
Plasmid detection and annotation
Using SPAdes v3.9.0 and SSPACE v2.0 (https://github.com/nsoranzo/sspace_basic), plasmid DNA sequence was identified and extracted from the whole sequence. Then, the selected scaffolds were analyzed on the PlasmidFinder (http://cge.cbs.dtu.dk/services/Plamidinder/) and Addgene (https://www.addgene.org/analyze-sequence/) servers. Moreover, the YKJ plasmid sequence was aligned and compared with the closest identified plasmid sequences using the BRIG v0.95 software. In addition, the plasmid DNA was annotated in RAST and Addgene servers.
Bacterial growth in presence of aromatic compounds
Various concentrations of aromatic compounds were each separately added to 10 ml of mineral salts medium (Fig. S9). The culture media were inoculated with a 3% inoculum obtained from a pre-culture (OD600 = 1), and incubated at 30 °C with shaking at 180 rpm. Growth was then assessed spectrophotometrically by measuring the optical density (OD) of the culture samples at 600 nm at specified time intervals (12 hours).
Bacterial substrate preference test
After determining the suitable concentrations of aromatic compounds for bacterial growth, the aromatic compounds preferred by the YKJ strain, as the best sole source of carbon and energy, were investigated. Therefore, selected concentrations of each aromatic compound was added to 10 ml of mineral salts medium (Fig. S10). The culture media were inoculated and incubated as mentioned above, and bacterial growth was measured at 600 nm at specified time intervals (12 hours), as mentioned previously.
Antibiotic resistance test
Several experiments were designed to investigate the resistance of the YKJ strain to antibiotics. LB agar medium was prepared with standard concentrations of five different antibiotics, namely ampicillin (100 μg), tetracycline (25 μg), kanamycin (50 μg), rifampicin (100 μg) and chloramphenicol (34 μg). The YKJ strain was then streaked onto LB agar medium containing the antibiotic. Moreover, the extracted pYKJ was transferred into E. coli DH5α cells using the heat shock method, as described previously69. E. coli transformants were then streaked onto LB agar media and incubated at 37 °C. In the next step, five single colonies of E. coli DH5α strain grown on LB agar medium were inoculated into five flasks congaing LB broth (10 ml), and incubated at 37 °C, with shaking at 180 rpm for 17 h. Afterwards, plasmid DNA was extracted using the Fermentas plasmid extraction kit (Fermentas/ThermoFisher Scientific, USA). Plasmid DNA extraction was approved by the agarose gel electrophoresis procedure. In addition, 50 µl of each culture medium was streaked onto LB agar plates containing ampicillin and chloramphenicol, so as to investigate antibiotic resistance of the E. coli transformants containing the pYKJ plasmid.
Data Availability
All obtained data within this study are included in this paper and its supplementary files. The whole genome sequencing project of P. pseudoalcaligenes YKJ strain has been announced in https://www.ncbi.nlm.nih.gov under the accession number of PTLV00000000 and BioProject code: PRJNA434488.
References
Johri, A. K. et al. Genetic manipulations of microorganisms for the degradation of hexachlorocyclohexane. FEMS microbiology reviews 19, 69–84 (1996).
Ren, S.-X., Fu, G., Xiu-Gao, J., Zeng, R. & Miao, Y.-G. Unique physiological and pathogenic features of Leptospira interrogans revealed by whole-genome sequencing. Nature 422, 888 (2003).
Shah, M. P. Microbiological Removal of Phenol by an Application of Pseudomonas spp. ETL. An Innovative Biotechnological Approach Providing Answers to the problems of FETP. Journal of Applied & Environmental Microbiology 1, 6–11 (2014).
Abril, M., Michan, C., Timmis, K. & Ramos, J. Regulator and enzyme specificities of the TOL plasmid-encoded upper pathway for degradation of aromatic hydrocarbons and expansion of the substrate range of the pathway. Journal of Bacteriology 171, 6782–6790 (1989).
Margesin, R., Fonteyne, P.-A. & Redl, B. Low-temperature biodegradation of high amounts of phenol by Rhodococcus spp. and basidiomycetous yeasts. Research in Microbiology 156, 68–75 (2005).
Euzéby, J. P. List of Bacterial Names with Standing in Nomenclature: a folder available on the Internet. International Journal of Systematic and Evolutionary Microbiology 47, 590–592 (1997).
Shingler, V., Powlowski, J. & Marklund, U. Nucleotide sequence and functional analysis of the complete phenol/3, 4-dimethylphenol catabolic pathway of Pseudomonas sp. strain CF600. Journal of bacteriology 174, 711–724 (1992).
Euzéby, J. P. List of Bacterial Names with Standing in Nomenclature: a folder available on the Internet. International journal of systematic bacteriology 47, 590–592 (1997).
Monias, B. L. Classification of bacterium alcaligenes, pyocyaneum, and fluorescens. The Journal of Infectious Diseases, 330–334 (1928).
O’Mahony, M. M., Dobson, A. D., Barnes, J. D. & Singleton, I. The use of ozone in the remediation of polycyclic aromatic hydrocarbon contaminated soil. Chemosphere 63, 307–314 (2006).
Yen, K.-M. et al. Cloning and characterization of a Pseudomonas mendocina KR1 gene cluster encoding toluene-4-monooxygenase. Journal of Bacteriology 173, 5315–5327 (1991).
Huertas, M.-J. et al. Cyanide metabolism of Pseudomonas pseudoalcaligenes CECT5344: role of siderophores (Portland Press Limited, 152–155 (2006).
Sasan Jahanshahi, B. Y. & Mahvash Khodabandeh. Biodegradation of Bisphenol ◌A in saline medium by indigenous bacteria. MS thesis, National Institute of Genetic Engineering and Biotechnology (2014).
Van Der Meer, J. R., De Vos, W., Harayama, S. & Zehnder, A. Molecular mechanisms of genetic adaptation to xenobiotic compounds. Microbiological reviews 56, 677–694 (1992).
Panke, S., Sánchez-Romero, J. M. & de Lorenzo, V. Engineering of Quasi-Natural Pseudomonas putida Strains for Toluene Metabolism through anortho-Cleavage Degradation Pathway. Applied and environmental microbiology 64, 748–751 (1998).
Hernandez, D., François, P., Farinelli, L., Østerås, M. & Schrenzel, J. De novo bacterial genome sequencing: millions of very short reads assembled on a desktop computer. Genome research 18, 802–809 (2008).
Arenghi, F. L., Berlanda, D., Galli, E., Sello, G. & Barbieri, P. Organization and regulation of metaCleavage pathway genes for toluene and o-xylene derivative degradation in Pseudomonas stutzeri OX1. Applied and environmental microbiology 67, 3304–3308 (2001).
Zhang, W. et al. A practical comparison of de novo genome assembly software tools for next-generation sequencing technologies. PloS one 6, e17915 (2011).
MacLean, D., Jones, J. D. & Studholme, D. J. Application of’next-generation’sequencing technologies to microbial genetics. Nature Reviews Microbiology 7, 287 (2009).
Albertsen, M. et al. Genome sequences of rare, uncultured bacteria obtained by differential coverage binning of multiple metagenomes. Nature biotechnology 31, 533 (2013).
Yao, X., He, W. & Lu, C.-D. Functional characterization of seven γ-glutamylpolyamine synthetase genes and the bauRABCD locus for polyamine and β-alanine utilization in Pseudomonas aeruginosa PAO1. Journal of bacteriology 193, 3923–3930 (2011).
Zeng, G., Ye, S. & Larson, T. J. Repressor for the sn-glycerol 3-phosphate regulon of Escherichia coli K-12: primary structure and identification of the DNA-binding domain. Journal of bacteriology 178, 7080–7089 (1996).
Kostakioti, M., Hadjifrangiskou, M., Pinkner, J. S. & Hultgren, S. J. QseC‐mediated dephosphorylation of QseB is required for expression of genes associated with virulence in uropathogenic Escherichia coli. Molecular microbiology 73, 1020–1031 (2009).
Sharma, V. K. & Casey, T. Escherichia coli O157: H7 lacking the qseBC-encoded quorum-sensing system outcompetes the parental strain in colonization of cattle intestines. Applied and environmental microbiology 80, 1882–1892 (2014).
Miller, M. B. & Bassler, B. L. Quorum sensing in bacteria. Annual Reviews in Microbiology 55, 165–199 (2001).
Benveniste, R. & Davies, J. Aminoglycoside antibiotic-inactivating enzymes in actinomycetes similar to those present in clinical isolates of antibiotic-resistant bacteria. Proceedings of the National Academy of Sciences 70, 2276–2280 (1973).
Ghosal, D., Ghosh, S., Dutta, T. K. & Ahn, Y. Current state of knowledge in microbial degradation of polycyclic aromatic hydrocarbons (PAHs): a review. Frontiers in microbiology 7, 1369 (2016).
Atlas, R. M. Petroleum biodegradation and oil spill bioremediation. Marine Pollution Bulletin 31, 178–182 (1995).
Nordlund, I. & Shingler, V. Nucleotide sequences of the meta-cleavage pathway enzymes 2-hydroxymuconic semialdehyde dehydrogenase and 2-hydroxymuconic semialdehyde hydrolase from Pseudomonas CF600. Biochimica et Biophysica Acta (BBA)-Gene Structure and Expression 1049, 227–230 (1990).
Cámara, B. et al. A gene cluster involved in degradation of substituted salicylates via ortho cleavage in Pseudomonas sp. strain MT1 encodes enzymes specifically adapted for transformation of 4-methylcatechol and 3-methylmuconate. Journal of bacteriology 189, 1664–1674 (2007).
Zhang, W., Yin, K. & Chen, L. Bacteria-mediated bisphenol A degradation. Applied microbiology and biotechnology 97, 5681–5689 (2013).
Ike, M., Chen, M. Y., Jin, C. S. & Fujita, M. Acute toxicity, mutagenicity, and estrogenicity of biodegradation products of bisphenol‐A. Environmental toxicology 17, 457–461 (2002).
Telke, A. A., Kalyani, D. C., Jadhav, U. U., Parshetti, G. K. & Govindwar, S. P. Purification and characterization of an extracellular laccase from a Pseudomonas sp. LBC1 and its application for the removal of bisphenol A. Journal of Molecular Catalysis B: Enzymatic 61, 252–260 (2009).
Evans, W. The Microbioloǵical Deǵradation of Aromatic Compounds. Microbiology 32, 177–184 (1963).
Sudarsan, S. et al. Dynamics of benzoate metabolism in Pseudomonas putida KT2440. Metabolic Engineering Communications 3, 97–110 (2016).
Arora, P. K. & Bae, H. Bacterial degradation of chlorophenols and their derivatives. Microbial Cell Factories 13, 31 (2014).
Jindrova, E., Chocova, M., Demnerova, K. & Brenner, V. Bacterial aerobic degradation of benzene, toluene, ethylbenzene and xylene. Folia microbiologica 47, 83–93 (2002).
Harayama, S. et al. Characterization of five genes in the upper-pathway operon of TOL plasmid pWW0 from Pseudomonas putida and identification of the gene products. Journal of bacteriology 171, 5048–5055 (1989).
Vogt, C., Kleinsteuber, S. & Richnow, H. H. Anaerobic benzene degradation by bacteria. Microbial biotechnology 4, 710–724 (2011).
Werlen, C., Kohler, H.-P. E. & van der Meer, J. R. The broad substrate chlorobenzene dioxygenase and cis-chlorobenzene dihydrodiol dehydrogenase of Pseudomonas sp. strain P51 are linked evolutionarily to the enzymes for benzene and toluene degradation. Journal of Biological Chemistry 271, 4009–4016 (1996).
Pollmann, K., Beil, S. & Pieper, D. H. Transformation of Chlorinated Benzenes and Toluenes byRalstonia sp. Strain PS12 tecA (Tetrachlorobenzene Dioxygenase) and tecB (Chlorobenzene Dihydrodiol Dehydrogenase) Gene Products. Applied and environmental microbiology 67, 4057–4063 (2001).
Anjum, N. A. et al. Phytotechnologies: remediation of environmental contaminants. (CRC Press, 2012).
Warhurst, A. & Fewson, C. Microbial metabolism and biotransformations of styrene. Journal of Applied Microbiology 77, 597–606 (1994).
Kirchner, U., Westphal, A. H., Müller, R. & van Berkel, W. J. Phenol hydroxylase from Bacillus thermoglucosidasius A7, a two-protein component monooxygenase with a dual role for FAD. Journal of Biological Chemistry 278, 47545–47553 (2003).
Mooney, A., Ward, P. G. & O’Connor, K. E. Microbial degradation of styrene: biochemistry, molecular genetics, and perspectives for biotechnological applications. Applied microbiology and biotechnology 72, 1 (2006).
Kukor, J. J. & Olsen, R. H. Complete nucleotide sequence of tbuD, the gene encoding phenol/cresol hydroxylase from Pseudomonas pickettii PKO1, and functional analysis of the encoded enzyme. Journal of bacteriology 174, 6518–6526 (1992).
Costa, A. S. et al. Environmental strategies to remove volatile aromatic fractions (BTEX) from petroleum industry wastewater using biomass. Bioresource Technology 105, 31–39 (2012).
Crozier-Reabe, K. & Moran, G. R. Form follows function: structural and catalytic variation in the class A flavoprotein monooxygenases. International journal of molecular sciences 13, 15601–15639 (2012).
McDonald, D. et al. An improved Greengenes taxonomy with explicit ranks for ecological and evolutionary analyses of bacteria and archaea. The ISME journal 6, 610 (2012).
Jolley, K. A., Chan, M.-S. & Maiden, M. C. mlstdbNet–distributed multi-locus sequence typing (MLST) databases. BMC bioinformatics 5, 86 (2004).
Yamamoto, S. & Harayama, S. Phylogenetic relationships of Pseudomonas putida strains deduced from the nucleotide sequences of gyrB, rpoD and 16S rRNA genes. International Journal of Systematic and Evolutionary Microbiology 48, 813–819 (1998).
Gomila, M., Peña, A., Mulet, M., Lalucat, J. & García-Valdés, E. Phylogenomics and systematics in Pseudomonas. Frontiers in microbiology 6, 214 (2015).
Xu, Z. & Hao, B. CVTree update: a newly designed phylogenetic study platform using composition vectors and whole genomes. Nucleic acids research 37, W174–W178 (2009).
Fronzes, R., Christie, P. J. & Waksman, G. The structural biology of type IV secretion systems. Nature Reviews Microbiology 7, 703 (2009).
Guglielmini, J., De La Cruz, F. & Rocha, E. P. Evolution of conjugation and type IV secretion systems. Molecular biology and evolution 30, 315–331 (2012).
Green, E. R. & Mecsas, J. Bacterial secretion systems–an overview. Microbiology spectrum 4 (2016).
Seoh, H. K. & Tai, P. C. Carbon source-dependent synthesis of SecB, a cytosolic chaperone involved in protein translocation across Escherichia coli membranes. Journal of bacteriology 179, 1077–1081 (1997).
Heeb, S. & Haas, D. Regulatory roles of the GacS/GacA two-component system in plant-associated and other gram-negative bacteria. Molecular plant-microbe interactions 14, 1351–1363 (2001).
Falke, J. J., Bass, R. B., Butler, S. L., Chervitz, S. A. & Danielson, M. A. The two-component signaling pathway of bacterial chemotaxis: a molecular view of signal transduction by receptors, kinases, and adaptation enzymes. Annual review of cell and developmental biology 13, 457–512 (1997).
Gooderham, W. J. & Hancock, R. E. Regulation of virulence and antibiotic resistance by two-component regulatory systems in Pseudomonas aeruginosa. FEMS microbiology reviews 33, 279–294 (2009).
Bourret, R. B., Hess, J. F., Borkovich, K. A., Pakula, A. A. & Simon, M. I. Protein phosphorylation in chemotaxis and two-component regulatory systems of bacteria. Journal of Biological Chemistry 264, 7085–7088 (1989).
Frank, J. A. et al. Critical evaluation of two primers commonly used for amplification of bacterial 16S rRNA genes. Applied and environmental microbiology 74, 2461–2470 (2008).
Moradi, M., Shariati, P., Tabandeh, F., Yakhchali, B. & Khaniki, G. B. Screening and isolation of powerful amylolytic bacterial strains. International Journal of Current Microbiology and Applied Sciences 3, 758–768 (2014).
Zerbino, D. R. & Birney, E. Velvet: algorithms for de novo short read assembly using de Bruijn graphs. Genome research 18, 821–829 (2008).
Klieve, A., Plumb, J. & Blackall, L. Isolation and characterization of an unusual bacterium, allied to the soil bacterium Bacillus benzoevorans, from feedlot manure pads in Australia. Letters in applied microbiology 29, 71–75 (1999).
Kanehisa, M., Sato, Y. & Morishima, K. BlastKOALA and GhostKOALA: KEGG tools for functional characterization of genome and metagenome sequences. Journal of molecular biology 428, 726–731 (2016).
Kanehisa, M., Furumichi, M., Tanabe, M., Sato, Y. & Morishima, K. KEGG: new perspectives on genomes, pathways, diseases and drugs. Nucleic acids research 45, D353–D361 (2016).
Langmead, B. & Salzberg, S. L. Fast gapped-read alignment with Bowtie 2. Nature methods 9, 357 (2012).
Chung, C., Niemela, S. L. & Miller, R. H. One-step preparation of competent Escherichia coli: transformation and storage of bacterial cells in the same solution. Proceedings of the National Academy of Sciences 86, 2172–2175 (1989).
Acknowledgements
This research received no specific grant from any funding agency in the public, commercial, or not-for-profit sectors. We would like to thank Dr. Parvin Shariati for the English editing of the manuscript.
Author information
Authors and Affiliations
Contributions
Bagher Yakhchali characterized the bacterial species (P. pseudoalcaligenes strain YKJ), and also contributed to study conception, project design, critically revised the article for important intellectual content and final approval of the version to be published. Maryam Safari contributed to study conception and design, analysis and interpretation of data, writing the first draft of the manuscript and also carried out laboratory work. Vahid Shariati J contributed by providing ideas in the analysis of data, project design and revising the article to be published.
Corresponding author
Ethics declarations
Competing Interests
The authors declare no competing interests.
Additional information
Publisher’s note: Springer Nature remains neutral with regard to jurisdictional claims in published maps and institutional affiliations.
Supplementary information
Rights and permissions
Open Access This article is licensed under a Creative Commons Attribution 4.0 International License, which permits use, sharing, adaptation, distribution and reproduction in any medium or format, as long as you give appropriate credit to the original author(s) and the source, provide a link to the Creative Commons license, and indicate if changes were made. The images or other third party material in this article are included in the article’s Creative Commons license, unless indicated otherwise in a credit line to the material. If material is not included in the article’s Creative Commons license and your intended use is not permitted by statutory regulation or exceeds the permitted use, you will need to obtain permission directly from the copyright holder. To view a copy of this license, visit http://creativecommons.org/licenses/by/4.0/.
About this article
Cite this article
Safari, M., Yakhchali, B. & Shariati.J, V. Comprehensive genomic analysis of an indigenous Pseudomonas pseudoalcaligenes degrading phenolic compounds. Sci Rep 9, 12736 (2019). https://doi.org/10.1038/s41598-019-49048-6
Received:
Accepted:
Published:
Version of record:
DOI: https://doi.org/10.1038/s41598-019-49048-6
This article is cited by
-
Phylloplane-Adapted Pseudomonas oryzihabitans as a biocontrol agent: omics insights into antibiosis and defense against bacterial blight of pomegranate
World Journal of Microbiology and Biotechnology (2025)
-
Unveiling a novel exopolysaccharide produced by Pseudomonas alcaligenes Med1 isolated from a Chilean hot spring as biotechnological additive
Scientific Reports (2024)
-
Genome sequence of Stenotrophomonas indicatrix CPHE1, a powerful phenanthrene-degrading bacterium
3 Biotech (2023)
-
Pseudomonas veronii strain 7–41 degrading medium-chain n-alkanes and polycyclic aromatic hydrocarbons
Scientific Reports (2022)
-
Current research on simultaneous oxidation of aliphatic and aromatic hydrocarbons by bacteria of genus Pseudomonas
Folia Microbiologica (2022)